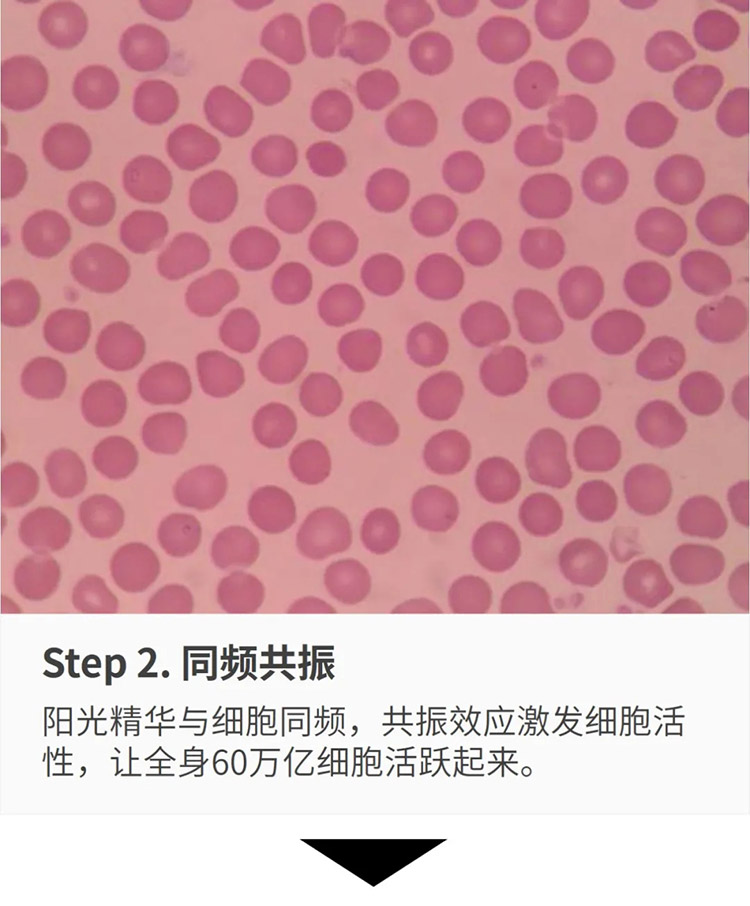
君康能阳光精华温暖腹部

发布时间:2021-07-31

肠道毒素是影响人体健康长寿的主要障碍
——诺贝尔医学奖获得者、俄罗斯微生物学与免疫学家梅契尼可夫在其著作《延年益寿》中明确提出,肠道健康就是世界上最好的长寿秘诀。
你的肠道健康吗?(请自测↓)

请注意!如果你出现任何1条或以上排便不畅的情况,说明肠道出现了健康问题,肠道毒素开始堆积了!
日积月累的肠毒堆积而成“可怕的宿便”

你知道吗?人的肠道有8-10米长,并且千褶百皱,平均每隔3.5厘米就有一个弯折,人们即使每天都排泄,也总会有一些食物残渣滞留在肠道的褶皱内,它们在细菌的作用下干结、腐败、发酵,日积月累,这些食物残渣最终形成厚达5-7毫米,重达 1-15公斤的黑色、恶臭、有毒的物质,并像锈一样牢牢地粘连在肠壁上,其坚硬程度与轮胎相似,它们慢慢侵蚀着我们的身体,这些有毒物质称之为宿便。

有毒的宿便不排出体外,会被人体反吸收。宿便堆积在肠道内发酵、腐败,并不断产生各种毒素、毒气,被肠粘膜吸收到血液并输送到身体各个细胞,首先造成肠内环境恶化、肠胃功能紊乱,继而引发内分泌失调、新陈代谢紊乱;接着,毒素使人身体变臭!变胖!变丑!变笨!失眠!衰老!最后引发各种病症,促使人体加速死亡!

俗话说
肠无渣,面如花
肠道病,半条命
肠道排毒,刻不容缓!
温热腹部,促进肠道蠕动
是让肠道顺畅排毒的有效方法!

君康能阳光精华
有助于提升肠道功能,排出肠毒!

腹为阴,腹部先天容易寒凝,寒湿气容易堆积。经常使用君康能阳光精华温暖腹部,可增加内脏的血流量,排出腹部寒湿,提升肠道内壁肌肉的张力及功能,促进肠道蠕动,从而调节便秘,改善肠道健康。
君康能阳光精华温热身体排寒湿的原理
▽
君康能萃取阳光精华
带来健康能量
太阳光既有“有害部分”,又有“有益部分”。君康能阳光屋萃取的是对人体健康有益的“阳光精华”。“阳光精华” 是人类赖以生存和维持健康必不可少的物质。

——温馨提示——
在享用君康能阳光精华的同时按揉腹部
排出肠毒的效果加倍
Tips: 揉腹的时候,注意寻找腹部的阻滞点,也许是一个硬块,或者一个痛点,或者是一个"水槽",或者是一个"气团",只要把它推开揉散,就会发现你的肠道毒素会顺畅排出来!有人一推就会打嗝放屁,那是清气在上升、浊气在下降,效果非常好!
揉腹手法教学



